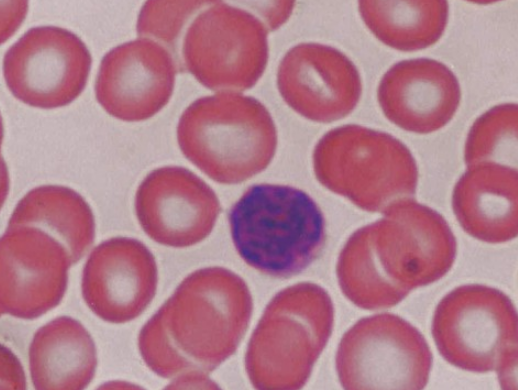

2
WeChat
微信客服
-
WeChat 微信客服
(打开微信扫一扫添加客服) -
微信扫描左侧二维码或加微信号
微信客服(1):bsaind -
微信扫描左侧二维码或加微信号
微信客服(2):bsamed -
耐心等待客服逐一处理
10-10点 - 查看更多
Global package for total price over 8000